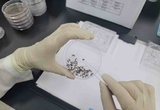

-

해빙기 택지개발·공공주택지구 ‘안전 사각지대’ 78건 적발
- 2026-04-03 15:16
- 강성규규 기자
-

경기도, "건설공사장 사고사망자 줄인다"
- 2026-04-03 15:15
- 강성규 기자
-

경기도청사 구내식당서 화재 발생…5분 만에 진화
- 2026-04-03 15:09
- 강성규 기자
-

화성시, 봄철 산불 예방 총력…집중 대응체계 돌입
- 2026-04-03 14:17
- 정일수 기자
-

오산시, 산불재난 대응체계 강화…재난안전대책본부 본격 가동
- 2026-04-03 14:09
- 정일수 기자
-

고양시, 서오릉서 '산불진화 통합훈련' 실시
- 2026-04-02 12:50
- 정일수 기자
-

안성시, ‘안성문화장 페스타’ 에너지 절약·안전 중심 축제로 개최
- 2026-04-02 12:29
- 정일수 기자
-

안성시, 고품질 안성쌀 생산 위한 품종별 적기 이앙기준 당부
- 2026-04-02 12:23
- 정일수 기자
-

평택시, 노동안전지킴이와 민관 합동점검 실시
- 2026-04-02 11:39
- 정일수 기자
-

유은혜 경기교육감 예비후보, 경기도민 정책 제안 접수
- 2026-04-02 11:35
- 강성규 기자
-

화성시 병점구보건소, 마약류·의약품 안전관리 강화
- 2026-04-02 11:01
- 정일수 기자
-

경기도 인권委, ‘행정복지센터 이용 중심의 접근성 보장’ 8대 권고안 마련
- 2026-04-02 10:17
- 강성규 기자
-

경기도보건환경연구원, 31개 시군 토양오염 우려지역 297곳 실태조사 실시
- 2026-04-02 10:12
- 강성규 기자
-

경기도, ‘경기귀농귀촌대학’ 신입생 100명 모집
- 2026-04-02 10:09
- 강성규 기자
-

평택시, ‘유해야생동물 피해방지단’ 안전교육 실시
- 2026-04-01 14:46
- 정일수 기자
-

안성시시설관리공단, 안성제2일반산업단지 공영주차장 본격 운영
- 2026-04-01 14:39
- 정일수 기자
-

안성시, 개인하수처리시설 집중 지도·점검 실시
- 2026-04-01 14:38
- 정일수 기자
-

화성시치매안심센터, 맞춤형 방문 프로그램 운영
- 2026-04-01 11:10
- 정일수 기자
-

화성시 동탄구, 동탄호수공원 일원 주차난 해소 위한 현장점검 실시
- 2026-04-01 11:07
- 정일수 기자
-

화성시, 서부지역 외국인 주민 참여 치안 협력 강화
- 2026-04-01 11:03
- 정일수 기자
-

화성시 4개 보건소, 친환경 방역소독사업 실시
- 2026-04-01 11:01
- 정일수 기자
-

경기지역 외식 프랜차이즈 등 대형음식점 위법행위 적발
- 2026-04-01 10:54
- 강성규 기자
-

화성시사회복지協, 복지소외계층 발굴 위한 ‘좋은이웃들 사업설명회’ 개최
- 2026-04-01 10:29
- 정일수 기자
-

일본뇌염·뎅기열 매개모기 감시사업 추진
- 2026-04-01 10:14
- 강성규 기자
-
1

[현장이슈]이상환 상임위원장,“‘수원군공항·경기국제공항 화성건설’반드시 저지할 것”
-
2

서울시, 개발행위허가 신청 접수‘행정사법’적용 시행
-
3

‘수원군공항 이전 특별법안’저지…화성시민 총집결 대규모 항의 집회
-
4

행정사법 적용, 경기지역 31개 시·군 측량업체 인허가 접수 불가 규정 지침 전달
-
5

광명시, 최초 학교복합시설 ‘광명동초 복합시설’내년 3월부터 운영
-
6

대한행정사회, 지방행정사간 ‘소통 불능’…‘갈등 격화’
-
7

[인터뷰]이상환 수원전투비행장 화성이전반대 범대위원장“힘의 논리로 화성시 얕잡아보고 무시하는 것 용납 못해”
-
8

[현장 이슈]수원전투비행장 화성이전반대 범대委, 군공항 이전 특별법안 심사 보류 요청
-
9

김상균 화성시의원, 입주예정아파트 현안 문제 해결 위한 간담회 개최
-
10

화성장애인누릴인권센터-화성시 시티투어,‘무장애 관광·북콘서트’ 29일 개최
- 지방자치광명시, 최초 학교복합시설 ‘광명동초 복합시설’내년 3월부터 운영
- 산업/경제군포 유한양행 부지 일원 공업지역 활성화 시범사업 순항…최근 예비타당성조사 통과
- 사회[현장이슈]이상환 상임위원장,“‘수원군공항·경기국제공항 화성건설’반드시 저지할 것”
- 지방의회김상균 화성시의원, 입주예정아파트 현안 문제 해결 위한 간담회 개최
- 문화/스포츠안산시, 실크로드&안산 PBA-LPBA 챔피언십 성공 개최 업무협약 체결
- 오피니언/피플강태형 경기도의원, 안산 대부해양본부‘우리밀 산업 육성 방안 간담회’참석
- 포토뉴스[포토뉴스]귀한‘소철꽃’ 핀 평택시자연테마식물원